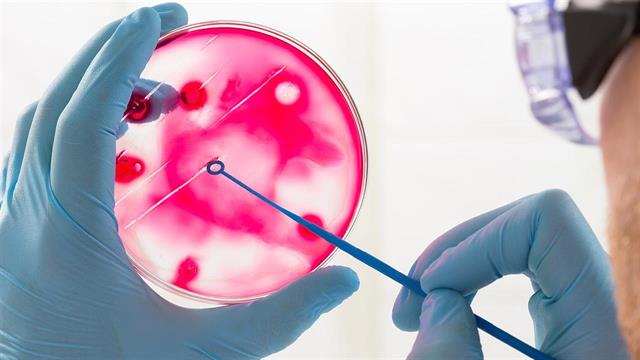
Ισραηλινοί επιστήμονες έσπασαν το ρεκόρ ανάπτυξης εμβρύου ποντικού εκτός μήτρας

Η νέα μέθοδος που αναπτύχθηκε στο Weizmann Institute, επιτρέπει σε βιολόγους να μάθουν καλύτερα από ποτέ πώς αναπτύσσονται τα θηλαστικά στα αρχικά στάδια της κύησης.
Βιολόγοι του Weizmann Institute of Science, πέτυχαν να αναπτύξουν ποντικούς εκτός μήτρας για περισσότερο διάστημα από ποτέ, σε μια σημαντική εξέλιξη που θα μπορούσε να συμβάλλει στην επιτάχυνση της έρευνας και στη μείωση της ανάγκης χρήσης πειραματόζωων, αναφέρει έρευνα στο περιοδικό Nature.
Tο ρεκόρ διατήρησης ενός εμβρύου σε δοκιμαστικό σωλήνα ήταν λιγότερο από μια εβδομάδα. Ο Καθηγητής Jacob Hanna, εργάζεται 7 χρόνια με αυτή την ομάδα για να επεκτείνει το χρόνο. Ανακάλυψαν τώρα διαδικασία σε δυο στάδια, που τους επιτρέπει να αναπτύσσουν ποντικούς για 11 ημέρες-πάνω από το ήμισυ της περιόδου κύησης των 20 ημερών.
Έτσι, οι επιστήμονες είχαν αρκετό χρόνο για να παρατηρήσουν πώς σχηματίζονται τα άκρα και τα όργανα.
Με τη νέα μέθοδο, οι επιστήμονες μπορούν να κοιτούν αυτά τα βήματα με λεπτομέρεια και να κάνουν διάφορα πειράματα που δεν ήταν εφικτά προηγουμένως.
Tο πρώτο βήμα ήταν να αφαιρεθούν έμβρυα από εγκύους ποντικούς πριν εμφυτευτούν στη μήτρα, όταν αποτελούνταν μόνο από σφαίρες των 250 βλαστικών κυττάρων.
Στη συνέχεια, οι μικροσκοπικές σφαίρες τοποθετήθηκαν σε ειδικό μέσο ανάπτυξης σε τρυβλίο petri, όπου τις επόμενες 2 ημέρες διαφοροποιήθηκαν σε 3 στρώματα, από τα οποία δημιουργούνται τα όργανα.
Όταν έφτασαν σε αυτό το βήμα, τα έμβρυα τοποθετήθηκαν σε δοκιμαστικούς σωλήνες γεμάτους από θρεπτικό διάλυμα.
Tοποθετήθηκαν σε τροχούς, που απαλά γυρνούσαν και κινούνταν για να μένουν εμβαπτισμένα τα έμβρυα.
Οι επιστήμονες επίσης έλεγχαν το οξυγόνο και το διοξείδιο του άνθρακα όπως και την πίεση των αερίων στο σωλήνα, ώστε να μοιάζουν με τις συνθήκες σε φυσιολογική μήτρα.
Οι επιστήμονες με γενετική επισήμανση ορισμένων κυττάρων μπορούσαν να παρακολουθούν με φωσφορίζον χρώμα την ανάπτυξη οργάνων.
Μπόρεσαν ακόμα να ενσωματώσουν με επιτυχία ανθρώπινα νευρικά κύτταρα στον εγκέφαλο των ποντικών.
Οι μέθοδοι μπορούν να βοηθήσουν επιστήμονες του μέλλοντος να κατανοήσουν πώς συμβαίνει η φυσιολογική και μη, ανάπτυξη στη μήτρα. Η νέα μέθοδος θα μπορούσε να χρησιμοποιηθεί για να φανεί το αποτέλεσμα της αλλαγής των συνθηκών στη μήτρα ή της επίδρασης ενός ιού που μολύνει το έμβρυο.
Πηγές:
Nature
Ειδήσεις υγείας σήμερα
Πρωινές συνήθειες που βοηθούν στη δυσκοιλιότητα
Βρώμη και κινόα: Πώς συγκρίνονται από άποψη πρωτεΐνης
Απ. Παπαλάκης: Ραγδαία αύξηση περιστατικών καρκίνου της ουροδόχου κύστης
ΠΟΥ: Ακριβής μέτρηση της αιμορραγίας μετά τον τοκετό για μείωση των θανάτων μητέρων
ΠΟΥ: Ακριβής μέτρηση της αιμορραγίας μετά τον τοκετό για μείωση των θανάτων μητέρων Σακχαρώδης διαβήτης κύησης: Έγκαιρη διάγνωση, ασφαλής εγκυμοσύνη
Σακχαρώδης διαβήτης κύησης: Έγκαιρη διάγνωση, ασφαλής εγκυμοσύνη Εγκυμοσύνη : Πολλές ώρες καθιστικής ζωής διπλασιάζουν τον κίνδυνο επιπλοκών [μελέτη]
Εγκυμοσύνη : Πολλές ώρες καθιστικής ζωής διπλασιάζουν τον κίνδυνο επιπλοκών [μελέτη] Το χασμουρητό είναι μεταδοτικό ακόμα και στο έμβρυο
Το χασμουρητό είναι μεταδοτικό ακόμα και στο έμβρυο Ασφαλής η εγκυμοσύνη για γυναίκες με μυασθένεια Gravis [μελέτη]
Ασφαλής η εγκυμοσύνη για γυναίκες με μυασθένεια Gravis [μελέτη] Τεχνητός πλακούντας ρίχνει φως στους κινδύνους από τα φάρμακα στην εγκυμοσύνη
Τεχνητός πλακούντας ρίχνει φως στους κινδύνους από τα φάρμακα στην εγκυμοσύνη Πρωινές συνήθειες που βοηθούν στη δυσκοιλιότητα
Πρωινές συνήθειες που βοηθούν στη δυσκοιλιότητα Βρώμη και κινόα: Πώς συγκρίνονται από άποψη πρωτεΐνης
Βρώμη και κινόα: Πώς συγκρίνονται από άποψη πρωτεΐνης Απ. Παπαλάκης: Ραγδαία αύξηση περιστατικών καρκίνου της ουροδόχου κύστης
Απ. Παπαλάκης: Ραγδαία αύξηση περιστατικών καρκίνου της ουροδόχου κύστης Τροφές που ενισχύουν την υγεία του εντέρου
Τροφές που ενισχύουν την υγεία του εντέρου Ρύζι, πατάτες και ζυμαρικά: Ποιο είναι χειρότερο για το σάκχαρο;
Ρύζι, πατάτες και ζυμαρικά: Ποιο είναι χειρότερο για το σάκχαρο; Με ποιες τροφές να συνδυάζω ρύζι, πατάτες και ζυμαρικά για να μην αυξάνεται απότομα το σάκχαρο
Με ποιες τροφές να συνδυάζω ρύζι, πατάτες και ζυμαρικά για να μην αυξάνεται απότομα το σάκχαρο Pharmathen: Βαθιά κρίση και μηδενισμός αποτίμησης από funds της Partners
Pharmathen: Βαθιά κρίση και μηδενισμός αποτίμησης από funds της Partners Καρπούζι: Ποια είναι τα οφέλη του στην υγεία
Καρπούζι: Ποια είναι τα οφέλη του στην υγεία Ισχυρή πρωτιά της ΔΗΚΙ στις εκλογές του Ιατρικού Συλλόγου Αθηνών - Ρεκόρ συμμετοχής
Ισχυρή πρωτιά της ΔΗΚΙ στις εκλογές του Ιατρικού Συλλόγου Αθηνών - Ρεκόρ συμμετοχής Ιατρικός Σύλλογος Θεσσαλονίκης: Σαρωτική επικράτηση της ΕΝΟ.ΣΥ. - Ν.Ι.Κ.Ι.
Ιατρικός Σύλλογος Θεσσαλονίκης: Σαρωτική επικράτηση της ΕΝΟ.ΣΥ. - Ν.Ι.Κ.Ι. Φαρμακοβιομηχανίες σκέφτονται να χτυπήσουν την πόρτα της Εθνικής Αρχής Διαφάνειας
Φαρμακοβιομηχανίες σκέφτονται να χτυπήσουν την πόρτα της Εθνικής Αρχής Διαφάνειας Οι απρόσμενες συνέπειες της ολοκληρωτικής παράλειψης της ζάχαρης από τη διατροφή [μελέτη]
Οι απρόσμενες συνέπειες της ολοκληρωτικής παράλειψης της ζάχαρης από τη διατροφή [μελέτη]